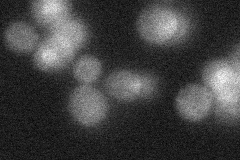
YGR171C
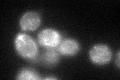
YGR171C

View description
Mitochondrial methionyl-tRNA synthetase (MetRS), functions as a monomer in mitochondrial protein synthesis; functions similarly to cytoplasmic MetRS although the cytoplasmic form contains a zinc-binding domain not found in Msm1p
Localization:
Intensity:
Fold change:
Significance:
-
C’ GFP library in SD

mitochondria23.13 -
N' NOP1pr-GFP in SD

mitochondria55.4434 -
N' TEF2pr-mCherry in SD

mitochondria87.9867 -
N' NATIVEpr-GFP in SD
cytosol22.8678 -
N' TEF2pr-VC and Cyto-VN in SD

#N/A0 -
C’ GFP library in SD+DTT
mitochondria28.951.25No -
C’ GFP library in SD+H2O2

mitochondria27.891.2No -
C’ GFP library in Starvation Media

mitochondria21.970.94No -
C’ GFP library on the background of Pup2-DaMP

mitochondria -
C’ GFP library on the background of CCT mutant

mitochondria28.89661.24891No
